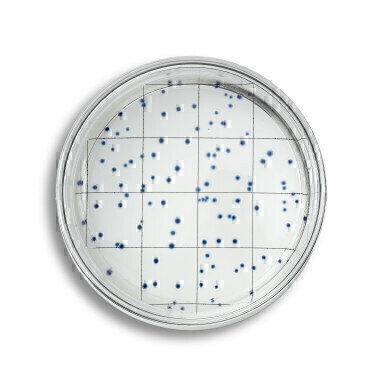
HPC Testing Platform Receives AFNOR NF Validation Certification

-
EasyDisc YEA from IDEXX provides fast, easy quantification of heterotrophic bacteria.
EasyDisc YEA from IDEXX provides fast, easy quantification of heterotrophic bacteria.
Laboratory products
HPC Testing Platform Receives AFNOR NF Validation Certification
May 03 2022
Fast, easy quantification of heterotrophic bacteria
EasyDisc YEATM from IDEXX, used for the enumeration of heterotrophic plate counts (HPC) at 22°C and 36°C in drinking water, has been granted the NF Validation by AFNOR Certification under the reference No 33/09 – 03/22.
The AFNOR Certification follows a study that was carried out by 14 independent expert laboratories. The performance of the EasyDisc method was judged equivalent to the standard method EN ISO 6222, when incubated at 22°C for 68 hours and when incubated at 36°C for 44 hours. Data from the study were then subjected to rigorous scrutiny by experts.
No media preparation, less than one minute of hands-on time
EasyDisc YEA offers an easy solution for HPC testing, with no agar preparation needed, and requires less than one minute of hands-on time to process a sample. Blue colonies reduce ambiguity of results, and colony counting is made easier by the integrated gridlines in the EasyDisc plate.
Proper use of HPC monitoring provides an insight into the effectiveness of ongoing supply chain quality and an indication of potential system failure, while warning of public health hazards.
EasyDisc is available in three different formulations to cover all HPC testing needs: PCA and YEA, which correlate with the pour plate method using plate count agar and yeast extract agar respectively for the testing of drinking and source water; and R2A that correlates with the pour plate method using Reasoner’s 2 agar for the testing of medical and/or pharmaceutical waters.
More information online
Digital Edition
Lab Asia Dec 2025
December 2025
Chromatography Articles- Cutting-edge sample preparation tools help laboratories to stay ahead of the curveMass Spectrometry & Spectroscopy Articles- Unlocking the complexity of metabolomics: Pushi...
View all digital editions
Events
Jan 21 2026 Tokyo, Japan
Jan 28 2026 Tokyo, Japan
Jan 29 2026 New Delhi, India
Feb 07 2026 Boston, MA, USA
Asia Pharma Expo/Asia Lab Expo
Feb 12 2026 Dhaka, Bangladesh


















